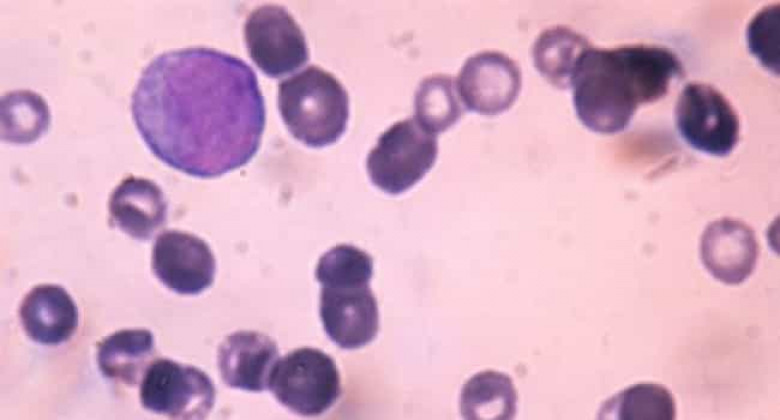

Գիտնականները հայտնել են արյան ագրեսիվ քաղցկեղի դեմ դեղամիջոց ստեղծելու հնարավորության մասին
ԼԱՅՖ
Արյան ծանր քաղցկեղային հիվանդությունը, որը հայտնի է որպես սուր միելոիդ լեյկոզ, հնարավոր է բուժել` մեծացնելով որոշակի տեսակի միկրոՌՆԹ-ների` գեների գործառույթները կարգավորող ռիբոնուկլեինային թթվի կարճ մոլեկուլների ակտիվությունը, պարզել են Ցինցինատիի համալսարանի գիտնականները: Հետազոտության արդյունքները հրապարակվել են Nature Communications ամսագրում, հայտնում է Lenta-ն:
Սուր միելոիդային լեյկոզը արյունաստեղծ հյուսվածքի չարորակ ուռուցք է, որը հանգեցնում է լեյկոցիտների նախնիներից առաջացող արյան սպիտակ գնդիկների (լեյկոզային բջիջների) արագ բազմացման: Դրանք կուտակվում են ոսկրածուծում` ճնշելով արյան նորմալ բջիջների զարգացումը, նվազեցնելով էրիտրոցիտների, թրոմբոցիտների եւ լեյկոցիտների քանակը: Իրենք` լեյկոզային բջիջները, ի տարբերություն նորմալ սպիտակ մարմինների, ի վիճակի չեն օրգանիզմը պաշտպանել վարակից:
Լաբորատոր մկների օգտագործմամբ նոր հետազոտության մեջ գիտնականները ցույց են տվել, որ սուր միելոիդային լեյկոզի զարգացումը կապված է miR-22 մոլեկուլի ակտիվության նվազման հետ: Այդ միացությունը դասվում է փոքր, չկոդավորող ՌՆԹ-ների (միկրոՌՆԹ-ների) դասին: ՄիկրոՌՆԹ-ները զուգավորվում են տեղեկատվական ՌՆԹ-ի հատվածների հետ` խոչընդոտելով դրա մասնակցությանը սպիտակուցի փոխանցման եւ սինթեզման գործընթացին:
Նախորդ աշխատանքները ցույց են տվել, որ miR-22-ն կապված է կաթնագեղձի քաղցկեղի եւ արյան հիվանդությունների հետ, որոնք կարող են նախորդել լեյկոզին: Հետազոտողները պարզել են, որ եթե մեծացվի այն գենի ակտիվությունը, որը պատասխանատու է miR-22-ի սինթեզի համար, լեյկոզային բջիջները սկսում են զարգացման, աճի եւ բազմացման դժվարություններ ունենալ: ՄիկրոՌՆԹ-ների տվյալ տեսակը ճնշում է քաղցկեղի հետ կապված որոշ գեների գործառույթները եւ արգելափակում է հիվանդությանը նպաստող նյութափոխանակային ուղիները:
Լեյկոզի զարգացումը պայմանավորված է miR-22-ի սինթեզի համար պատասխանատու ԴՆԹ-ի կորստով, այն հնարավոր է վերականգնել, եթե ոսրկրածուծի բջիջների մեջ ներմուծվեն միկրոՌՆԹ-ներ կրող նանոմասնիկներ:

 Ընթրիքի ժամանակ Թրամփի դեմ մահափորձի մեջ մեղադրվողը գտնվում է ինքնասպանության կանխման խիստ սահմանափակումների տակ
Ընթրիքի ժամանակ Թրամփի դեմ մահափորձի մեջ մեղադրվողը գտնվում է ինքնասպանության կանխման խիստ սահմանափակումների տակ Միացե՛ք մեզ` կառուցելու վաղվա օրը միասին․ՀՃԿ ղեկավար Արսեն Վարդանյան
Միացե՛ք մեզ` կառուցելու վաղվա օրը միասին․ՀՃԿ ղեկավար Արսեն Վարդանյան Սամվել Կարապետյանը հետագա միջազգային հարաբերությունների մասին
Սամվել Կարապետյանը հետագա միջազգային հարաբերությունների մասին «Հեզբոլլահի» նոր հզոր զենքը կարողանում է աննկատ մնալ Իսրայելից. CNN
«Հեզբոլլահի» նոր հզոր զենքը կարողանում է աննկատ մնալ Իսրայելից. CNN ԱՄՆ-ը ցանկանում է չեղարկել Գերմանիայում Tomahawk hրթիռների տեղակայման մասին որոշումը
ԱՄՆ-ը ցանկանում է չեղարկել Գերմանիայում Tomahawk hրթիռների տեղակայման մասին որոշումը Ռուսաստանը նախընտրում է Ուկրաինայի հարցով նպատակներին հասնել գործարքի միջոցով. Պեսկով
Ռուսաստանը նախընտրում է Ուկրաինայի հարցով նպատակներին հասնել գործարքի միջոցով. Պեսկով Օգտագործելու ենք մեր բոլոր հնարավորությունները երկարատև խաղաղություն ունենալու համար․ Կարապետյան
Օգտագործելու ենք մեր բոլոր հնարավորությունները երկարատև խաղաղություն ունենալու համար․ Կարապետյան Ադրբեջանի տարածքով Հայաստան կուղարկվի 8 վագոն պարարտանյութ
Ադրբեջանի տարածքով Հայաստան կուղարկվի 8 վագոն պարարտանյութ
 Հայրենասիրությունը պետք է լինի երիտասարդների առաջին նշաձողը․ Սամվել Կարապետյան
Հայրենասիրությունը պետք է լինի երիտասարդների առաջին նշաձողը․ Սամվել Կարապետյան Իրանը սկսել է կրճատել նավթի արդյունահանումը՝ ԱՄՆ-ի կողմից շրջափակման պատճառով․ Bloomberg
Իրանը սկսել է կրճատել նավթի արդյունահանումը՝ ԱՄՆ-ի կողմից շրջափակման պատճառով․ Bloomberg Հունիսի ութին դուք միանգամից կզգաք Ադրբեջանի խոսույթի փոփոխությունը․ Սամվել Կարապետյան
Հունիսի ութին դուք միանգամից կզգաք Ադրբեջանի խոսույթի փոփոխությունը․ Սամվել Կարապետյան Հորոսկոպ. ի՞նչն է խանգարում Կենդանակերպի նշաններին իրենց երազանքների ճանապարհին
Հորոսկոպ. ի՞նչն է խանգարում Կենդանակերպի նշաններին իրենց երազանքների ճանապարհին 21-ամյա Ռոբերտ Մ.-ն տեղում մահացել է
21-ամյա Ռոբերտ Մ.-ն տեղում մահացել է Վստահ եղեք որ մենք հաղթելու ենք․ Սամվել Կարապետյան
Վստահ եղեք որ մենք հաղթելու ենք․ Սամվել Կարապետյան ԱՄՆ-ի և Իսրայելի հարվածների հետևանքով Իրանում զnհվել է 4,000 խաղաղ բնակիչ. Խամենեիի ներկայացուցիչ
ԱՄՆ-ի և Իսրայելի հարվածների հետևանքով Իրանում զnհվել է 4,000 խաղաղ բնակիչ. Խամենեիի ներկայացուցիչ Վանաձոր քաղաքը և Լոռու մարզը լինելու են իմ ուշադրության կենտրոնում․ Սամվել Կարապետյան
Վանաձոր քաղաքը և Լոռու մարզը լինելու են իմ ուշադրության կենտրոնում․ Սամվել Կարապետյան «Պորտուն»՝ Պորտուգալիայի չեմպիոն
«Պորտուն»՝ Պորտուգալիայի չեմպիոն
 Ավտովթար Սևան-Մարտունի ավտոճանապարհին
Ավտովթար Սևան-Մարտունի ավտոճանապարհին Հունաստանի նախագահն այցելել է Ծիծեռնակաբերդ՝ հարգելու Ցեղասպանության զոհերի հիշատակը
Հունաստանի նախագահն այցելել է Ծիծեռնակաբերդ՝ հարգելու Ցեղասպանության զոհերի հիշատակը Շատ լավ ճաշակ ունեք, արագ, շուտ կողմնորոշվող ամուսին ունեք. Կարապետյանը կատակում է երիտասարդների հետ հանդիպմանը
Շատ լավ ճաշակ ունեք, արագ, շուտ կողմնորոշվող ամուսին ունեք. Կարապետյանը կատակում է երիտասարդների հետ հանդիպմանը
 Թալին-Սասնաշեն ճանապարհին մեքենան գլխիվայր հայտնվել է երթևեկելի գոտուց դուրս. վիրավոր կա
Թալին-Սասնաշեն ճանապարհին մեքենան գլխիվայր հայտնվել է երթևեկելի գոտուց դուրս. վիրավոր կա Ի՞նչ պետք է անի դեղին մամուլի ղեկավարը. իր անելիքը եղել է շանտաժը, իր գրդոն անելը. Կարապետյան
Ի՞նչ պետք է անի դեղին մամուլի ղեկավարը. իր անելիքը եղել է շանտաժը, իր գրդոն անելը. Կարապետյան
 Վոլոդիմիր Զելենսկին ժամանել է Երևան
Վոլոդիմիր Զելենսկին ժամանել է Երևան Դուք առաջին հերթին պետք է փոխեք Փաշինյանին. Սամվել Կարապետյան
Դուք առաջին հերթին պետք է փոխեք Փաշինյանին. Սամվել Կարապետյան
 Մենք Հայաստանը դարձնելու ենք 10 մլն հայերի հայրենիքը․ Սամվել Կարապետյան
Մենք Հայաստանը դարձնելու ենք 10 մլն հայերի հայրենիքը․ Սամվել Կարապետյան  Մեր Եկեղեցին կզբաղեցնի այն տեղը, որին արժանի է. Սամվել Կարապետյան
Մեր Եկեղեցին կզբաղեցնի այն տեղը, որին արժանի է. Սամվել Կարապետյան Հունաստանի նախագահը ժամանեց Երևան
Հունաստանի նախագահը ժամանեց Երևան
 ԵՄ գագաթնաժողով, վիզաներ, խոստումներ․ Մակրոնի դերը Արցախն ու Հայաստանը պաշտպանելու գործում
ԵՄ գագաթնաժողով, վիզաներ, խոստումներ․ Մակրոնի դերը Արցախն ու Հայաստանը պաշտպանելու գործում
 Մեր պայքարը Մեծ Հայքի արժեհամակարգի վերածնունդն է` միասնություն, ուժ և ամուր պետականություն. «Համահայկական ճակատ»Շարժում
Մեր պայքարը Մեծ Հայքի արժեհամակարգի վերածնունդն է` միասնություն, ուժ և ամուր պետականություն. «Համահայկական ճակատ»Շարժում Ի՞նչ փոխարժեքներ են սահմանվել այսօր՝ մայիսի 3-ին
Ի՞նչ փոխարժեքներ են սահմանվել այսօր՝ մայիսի 3-ին
 3-ը փոփոխության թիվն է. «Ուժեղ Հայաստան» կուսակցության խորհրդի անդամ Նարեկ Կարապետյան
3-ը փոփոխության թիվն է. «Ուժեղ Հայաստան» կուսակցության խորհրդի անդամ Նարեկ Կարապետյան Շիրակի մարզում՝ Սառնաղբյուրից մինչև Գյումրի, մարդկանց հետ հանդիպումները լի էին անկեղծությամբ, պարզ ու բաց խոսակցություններով. Գագիկ Ծառուկյան (տեսանյութ)
Շիրակի մարզում՝ Սառնաղբյուրից մինչև Գյումրի, մարդկանց հետ հանդիպումները լի էին անկեղծությամբ, պարզ ու բաց խոսակցություններով. Գագիկ Ծառուկյան (տեսանյութ)
 «Ուժեղ Հայաստան» կուսակցության առաջնորդ Սամվել Կարապետյանի հանդիպումը երիտասարդների հետ
«Ուժեղ Հայաստան» կուսակցության առաջնորդ Սամվել Կարապետյանի հանդիպումը երիտասարդների հետ Հայտնի է` որ թվերի ներքո հանդես կգան քաղաքական ուժերը ԱԺ ընտրություններին
Հայտնի է` որ թվերի ներքո հանդես կգան քաղաքական ուժերը ԱԺ ընտրություններին
 Ազատությունը չի կարող լիարժեք լինել, երբ այն ուղեկցվում է վախnվ, ճնշմամբ և անվստահությամբ․ Նաիրի Սարգսյանի ուղերձը՝ Մամուլի ազատության համաշխարհային օրվա առթիվ
Ազատությունը չի կարող լիարժեք լինել, երբ այն ուղեկցվում է վախnվ, ճնշմամբ և անվստահությամբ․ Նաիրի Սարգսյանի ուղերձը՝ Մամուլի ազատության համաշխարհային օրվա առթիվ
 Մեկնարկել է կամավորների հերթագրումը՝ Հատիսի գագաթին վեր խոյացող Հիսուս Քրիստոսի արձանի շինարարությանը մասնակցելու համար
Մեկնարկել է կամավորների հերթագրումը՝ Հատիսի գագաթին վեր խոյացող Հիսուս Քրիստոսի արձանի շինարարությանը մասնակցելու համար Հայաստան է ժամանել Բուլղարիայի Հանրապետության նախագահ Իլիանա Յոտովան
Հայաստան է ժամանել Բուլղարիայի Հանրապետության նախագահ Իլիանա Յոտովան
 Մահացել է Հասմիկ Մուրադյանը
Մահացել է Հասմիկ Մուրադյանը Հայաստան է ժամանել Կանադայի վարչապետ Մարկ Քարնին
Հայաստան է ժամանել Կանադայի վարչապետ Մարկ Քարնին
 ԼՀԿ թիմը Գյումրիում է
ԼՀԿ թիմը Գյումրիում է Չեմ կարող պատկերացնել, որ Իրանի ուղարկած նոր ծրագիրը ընդունելի կլինի․ Թրամփ
Չեմ կարող պատկերացնել, որ Իրանի ուղարկած նոր ծրագիրը ընդունելի կլինի․ Թրամփ
 ՈւՂԻՂ. Կուսակցություններն ի՞նչ համարների ներքո կլինեն քվեաթերթիկում. վիճակահանությունը սկսված է
ՈւՂԻՂ. Կուսակցություններն ի՞նչ համարների ներքո կլինեն քվեաթերթիկում. վիճակահանությունը սկսված է Հայաստանը պետք է դադարեցնի երկու լարի վրա խաղալու իր քաղաքականությունը, կանգնի Ռուսաստանի կողքին և թույլ չտա, որպեսզի Արևմուտքը քանդի մեր տարածաշրջանի անվտանգության ճարտարապետությունը․ Մհեր Ավետիսյան
Հայաստանը պետք է դադարեցնի երկու լարի վրա խաղալու իր քաղաքականությունը, կանգնի Ռուսաստանի կողքին և թույլ չտա, որպեսզի Արևմուտքը քանդի մեր տարածաշրջանի անվտանգության ճարտարապետությունը․ Մհեր Ավետիսյան Իրանն ԱՄՆ-ին առաջարկել է մեկ ամսվա ընթացքում պայմանավորվել շրջափակման վերացման շուրջ. Axios
Իրանն ԱՄՆ-ին առաջարկել է մեկ ամսվա ընթացքում պայմանավորվել շրջափակման վերացման շուրջ. Axios
 Աֆրիկայի արևային էներգիայի բումը խթանվում է էժան չինական վահանակներով, սակայն այդ դարաշրջանն ավարտվում է
Աֆրիկայի արևային էներգիայի բումը խթանվում է էժան չինական վահանակներով, սակայն այդ դարաշրջանն ավարտվում է Եվրոպական քաղաքական համայնքի 8-րդ գագաթնաժողովին մասնակցելու նպատակով Հայաստան են ժամանել մի շարք երկրների ներկայացուցիչներ
Եվրոպական քաղաքական համայնքի 8-րդ գագաթնաժողովին մասնակցելու նպատակով Հայաստան են ժամանել մի շարք երկրների ներկայացուցիչներ
 Տիգրան Բարսեղյանի հաղթական գոլը 8-րդ անընդմեջ չեմպիոնությունը պարգևեց Սլովանին
Տիգրան Բարսեղյանի հաղթական գոլը 8-րդ անընդմեջ չեմպիոնությունը պարգևեց Սլովանին
 Հրդեh Կուրղինյան փողոցում․ կան տnւժածներ
Հրդեh Կուրղինյան փողոցում․ կան տnւժածներ
 ՀՀ տարածքում ավտոճանապարհները հիմնականում անցանելի են
ՀՀ տարածքում ավտոճանապարհները հիմնականում անցանելի են
Ողբերգական ավտովթար՝ Շիրակի մարզում. 21-ամյա վարորդը մահացել է
Ողբերգական ավտովթար՝ Շիրակի մարզում. 21-ամյա վարորդը մահացել է 





